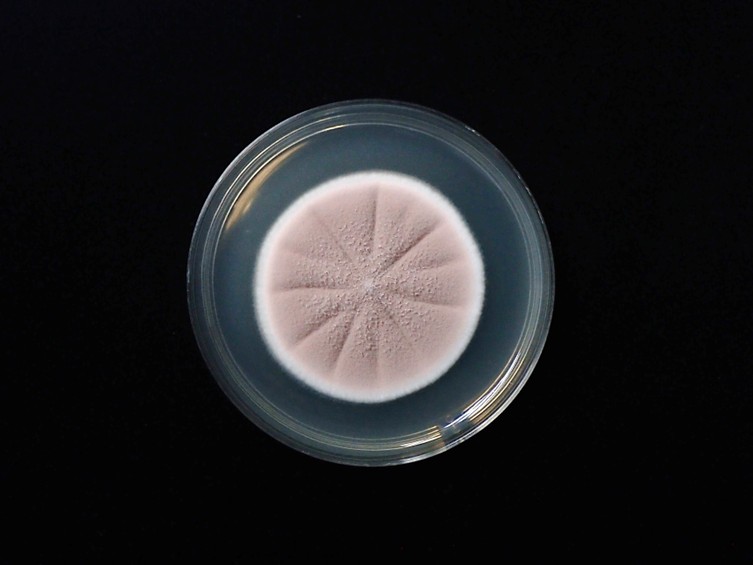

Holotype:
VENEZUELA, Caracas, from soil, 2008, C. Hartung, S. Mata-Essayag, holotype IMI 500328, ex-type living culture CBS 128677 and FMR 10376.
Habitat:
Soil.
Host:
Soil.
Culture characteristics:
Colonies on PDA attaining a diam of 30–40 mm in 14 d, purplish grey, cottony with high mycelial density, margins regular, radially sulcate, numerous
PDA attaining a diam of 30–40 mm in 14 d, purplish grey, cottony with high mycelial density, margins regular, radially sulcate, numerous  conidiophores resulting in a powdery texture, colony reverse producing a light yellow diffuse pigment. Vegetative hyphae smoo. Conidiophores forming verticillate branches with terminal whorls of three to six
conidiophores resulting in a powdery texture, colony reverse producing a light yellow diffuse pigment. Vegetative hyphae smoo. Conidiophores forming verticillate branches with terminal whorls of three to six  phialides or singly arising from hyphae. Phialides awl-shaped, cylindrical ellipsoidal or swollen basal portion into distinct neck, 5–15 × 2–3 μm.
phialides or singly arising from hyphae. Phialides awl-shaped, cylindrical ellipsoidal or swollen basal portion into distinct neck, 5–15 × 2–3 μm.  Conidia subglobose with apiculate base or limoniform, 2–3.5 × 2–3 mm, dry, in long chain.
Conidia subglobose with apiculate base or limoniform, 2–3.5 × 2–3 mm, dry, in long chain.
Reference:
Perdomo H, Cano J, Gené J, et al. (2013). Polyphasic analysis of Purpureocillium lilacinum isolates from different origins and proposal of the new species Purpureocillium lavendulum. Mycologia 105: 151–161.
DOI: https://doi.org/10.3852/11-190Species |
Strain |
Compound |
Pubchem CID |
Biological activity |
Reference |
|---|
|
Strain |
MH864976 |
|---|---|
| CBS 128677 | - |